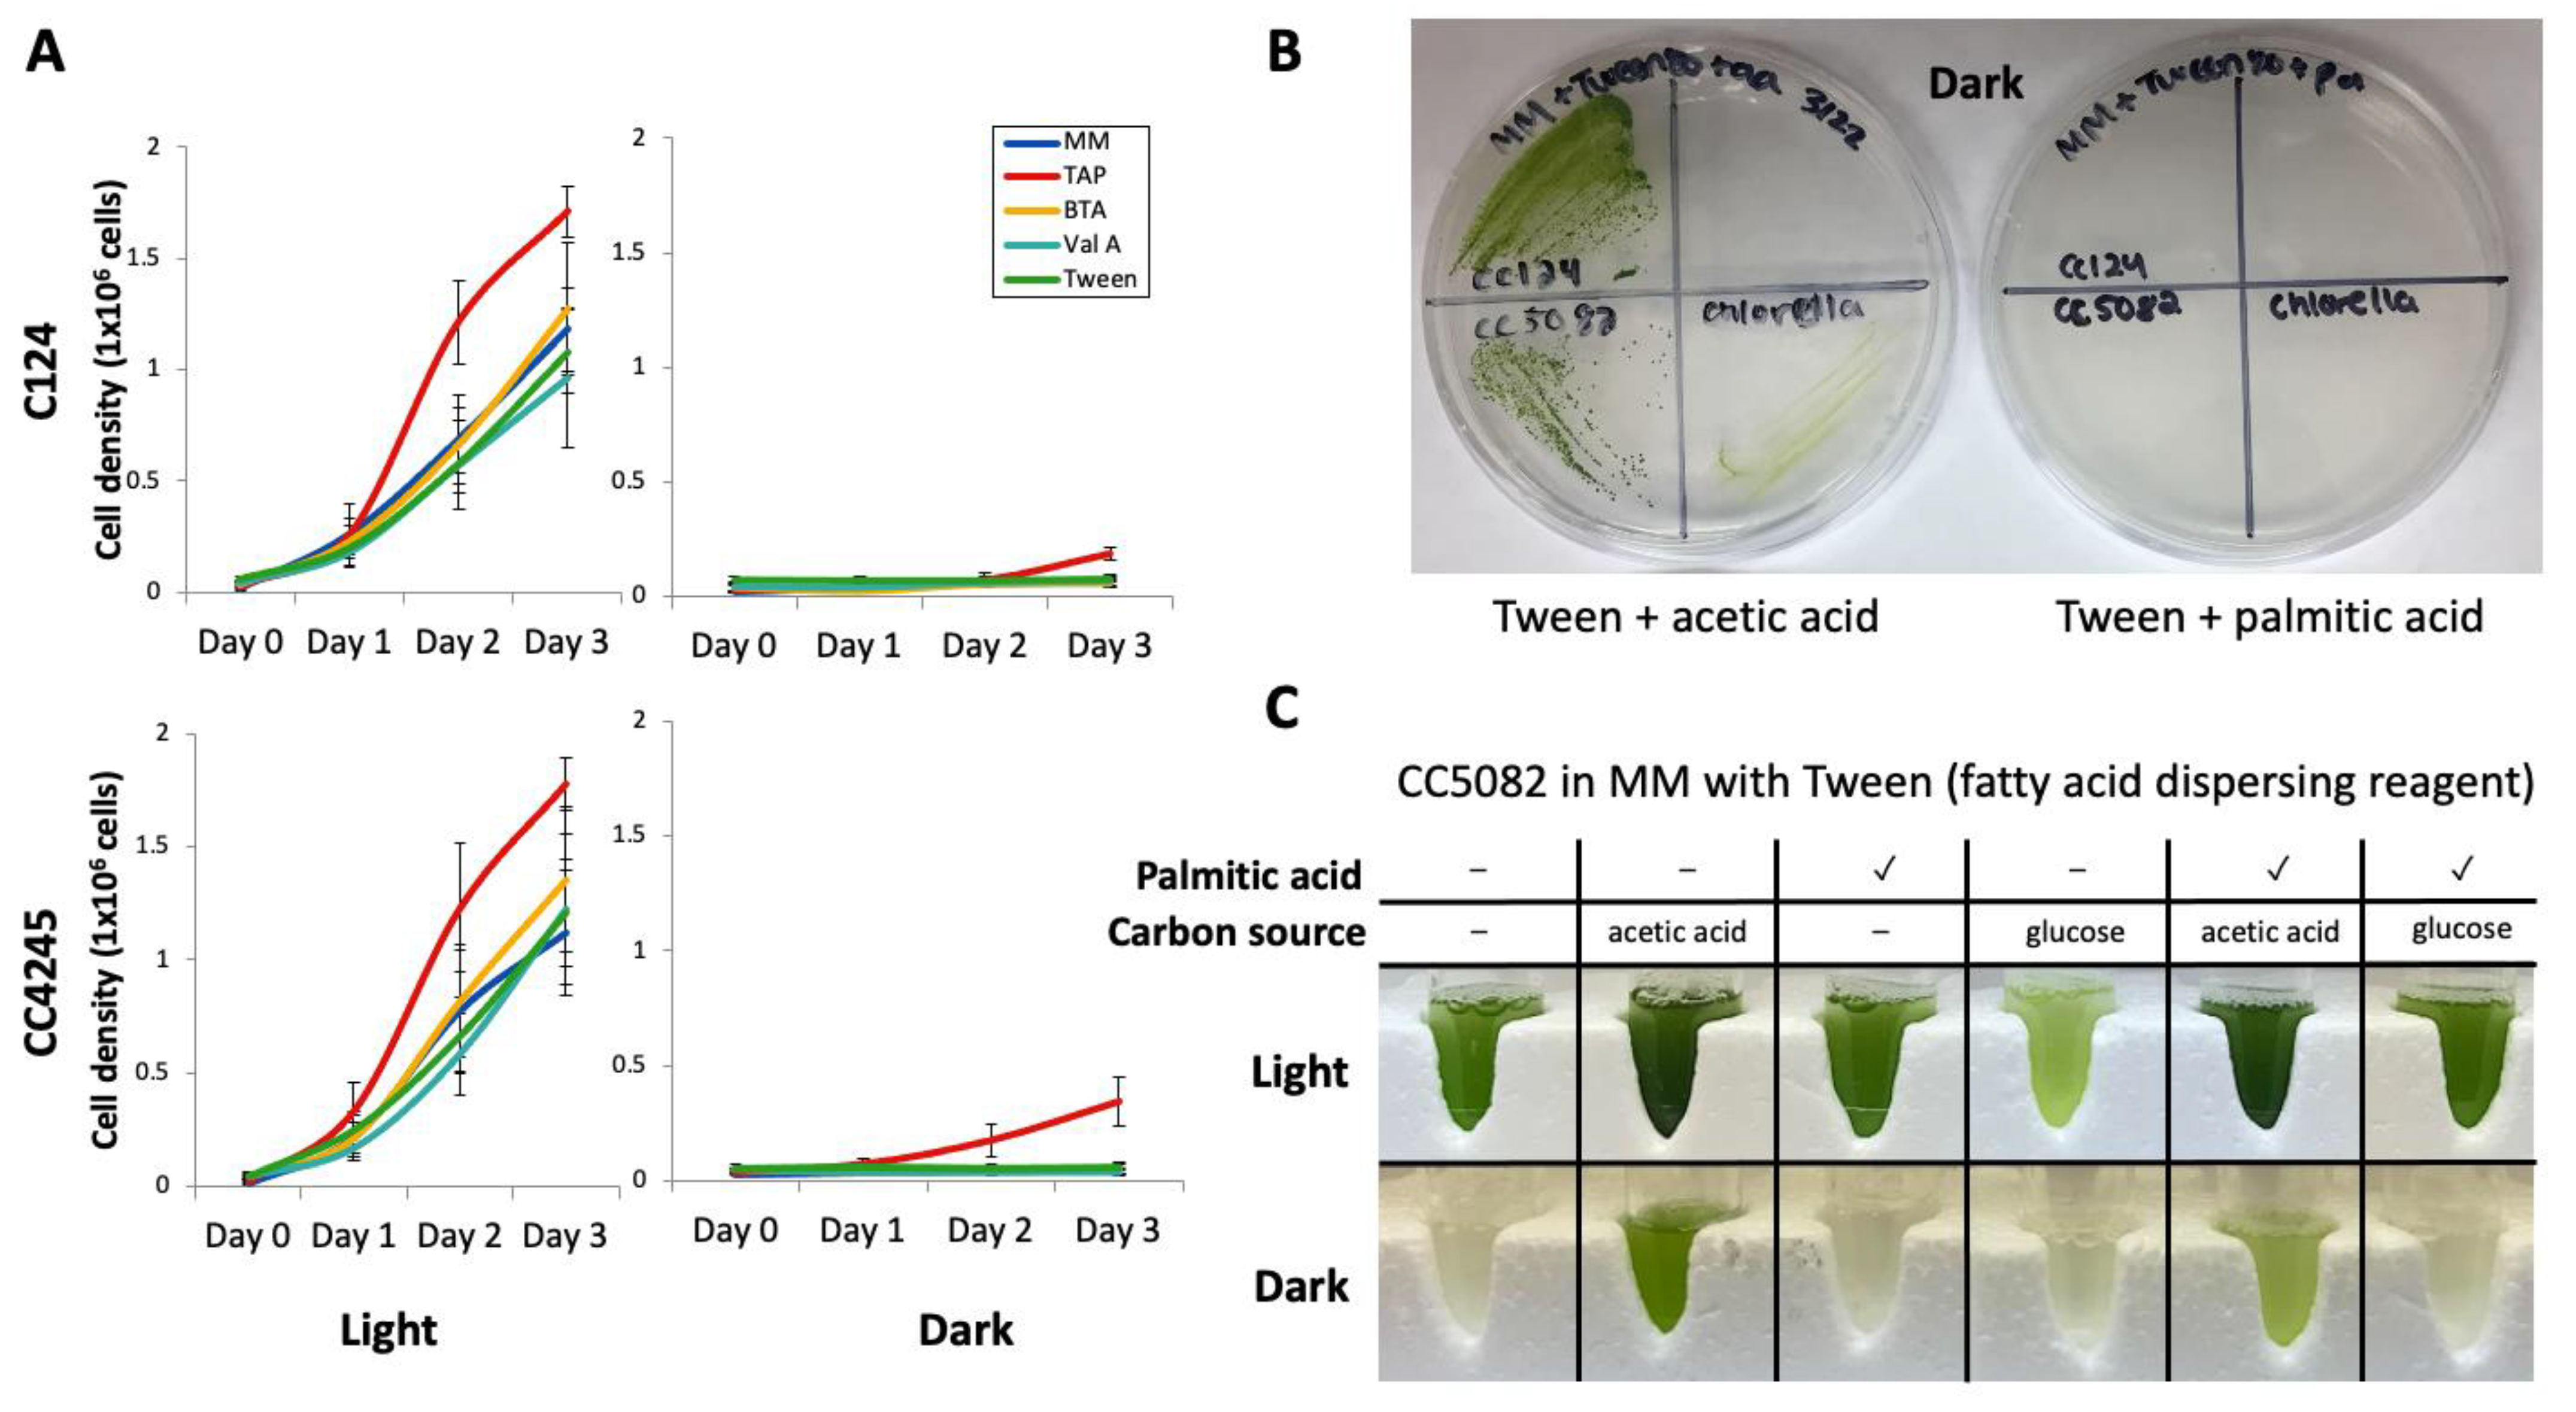
Cells 11 02724 g001

Chlamydomonas reinhardtii Alternates Peroxisomal Contents in Response to Trophic Conditions
Abstract
:1. Introduction
2. Materials and Methods
2.1. Algal Strains and Culture Conditions
2.2. Fatty Acid Preparations
2.3. Fluorescent Protein Constructs and Algal Transformation
2.4. Fluorescence Microscopy
2.5. Compartment Analysis
2.6. Identification of PEX Genes
3. Results
3.2. C. Reinhardtii Has a Complete Set of Peroxisome Biogenesis Factor Genes
3.3. C. Reinhardtii Contains Peroxisomes with Varying Contents
4. Discussion
4.2. Physical Separation of Exogenously Added Fatty Acids and Enzymes for β-oxidation and Glyoxylate Cycle
4.3. Changes in Peroxisomal Contents by Light Conditions
4.4. Peroxisomal Function and Evolution in Green Algae
5. Conclusions
Supplementary Materials
Author Contributions
Funding
Data Availability Statement
Acknowledgments
Conflicts of Interest
References
- Hu, Q.; Sommerfeld, M.; Jarvis, E.; Ghirardi, M.; Posewitz, M.; Seibert, M.; Darzins, A. Microalgal triacylglycerols as feedstocks for biofuel production: Perspectives and advances. Plant. J. 2008, 54, 621–639. [Google Scholar] [CrossRef] [PubMed]
- Radakovits, R.; Jinkerson, R.E.; Darzins, A.; Posewitz, M.C. Genetic engineering of algae for enhanced biofuel production. Eukaryot Cell 2010, 9, 486–501. [Google Scholar] [CrossRef] [PubMed]
- Fairley, P. Introduction: Next generation biofuels. Nature 2011, 474, S2–S5. [Google Scholar] [CrossRef] [PubMed]
- Rochaix, J.-D. Chlamydomonas reinhardtii as the photosynthetic yeast. Annu. Rev. Genet. 1995, 29, 209–230. [Google Scholar] [CrossRef]
- Boyle, N.R.; Sengupta, N.; Morgan, J.A. Metabolic flux analysis of heterotrophic growth in Chlamydomonas reinhardtii. PLoS ONE 2017, 12, e0177292. [Google Scholar] [CrossRef]
- Lauersen, K.J.; Willamme, R.; Coosemans, N.; Joris, M.; Kruse, O.; Remacle, C. Peroxisomal microbodies are at the crossroads of acetate assimilation in the green microalga Chlamydomonas reinhardtii. Algal Res. 2016, 16, 266–274. [Google Scholar] [CrossRef]
- Graham, I.A.; Eastmond, P.J. Pathways of straight and branched chain fatty acid catabolism in higher plants. Prog. Lipid Res. 2002, 41, 156–181. [Google Scholar] [CrossRef]
- Goepfert, S.; Poirier, Y. Beta-oxidation in fatty acid degradation and beyond. Curr. Opin. Plant. Biol 2007, 10, 245–251. [Google Scholar] [CrossRef]
- Zhao, M.; Zhang, H.; Yan, H.; Qiu, L.; Baskin, C.C. Mobilization and Role of Starch, Protein, and Fat Reserves during Seed Germination of Six Wild Grassland Species. Front. Plant. Sci 2018, 9, 234. [Google Scholar] [CrossRef]
- Cooper, T.G.; Beevers, H. Beta oxidation in glyoxysomes from castor bean endosperm. J. Biol Chem 1969, 244, 3514–3520. [Google Scholar] [CrossRef]
- Tolbert, N.E. Metabolic pathways in peroxisomes and glyoxysomes. Annu. Rev. Biochem. 1981, 50, 133–157. [Google Scholar] [CrossRef]
- Lodhi, I.J.; Semenkovich, C.F. Peroxisomes: A nexus for lipid metabolism and cellular signaling. Cell Metab. 2014, 19, 380–392. [Google Scholar] [CrossRef]
- Smith, J.J.; Aitchison, J.D. Peroxisomes take shape. Nat. Rev. Mol. Cell Biol. 2013, 14, 803–817. [Google Scholar] [CrossRef]
- Chowdhary, G.; Kataya, A.R.; Lingner, T.; Reumann, S. Non-canonical peroxisome targeting signals: Identification of novel PTS1 tripeptides and characterization of enhancer elements by computational permutation analysis. BMC Plant. Biol. 2012, 12, 142. [Google Scholar] [CrossRef]
- Petriv, O.I.; Tang, L.; Titorenko, V.I.; Rachubinski, R.A. A new definition for the consensus sequence of the peroxisome targeting signal type 2. J. Mol. Biol. 2004, 341, 119–134. [Google Scholar] [CrossRef]
- Kato, N.; Nelson, G.; Lauersen, K.J. Subcellular Localizations of Catalase and Exogenously Added Fatty Acid in Chlamydomonas reinhardtii. Cells 2021, 10, 1940. [Google Scholar] [CrossRef]
- Hayashi, Y.; Sato, N.; Shinozaki, A.; Watanabe, M. Increase in peroxisome number and the gene expression of putative glyoxysomal enzymes in Chlamydomonas cells supplemented with acetate. J. Plant. Res. 2015, 177–185. [Google Scholar] [CrossRef]
- Kong, F.; Liang, Y.; Légeret, B.; Beyly-Adriano, A.; Blangy, S.; Haslam, R.P.; Napier, J.A.; Beisson, F.; Peltier, G.; Li-Beisson, Y. Chlamydomonas carries out fatty acid β-oxidation in ancestral peroxisomes using a bona fide acyl-CoA oxidase. Plant. J. 2017. [Google Scholar] [CrossRef]
- Kato, N.; Dong, T.; Bailey, M.; Lum, T.; Ingram, D. Triacylglycerol mobilization is suppressed by brefeldin A in Chlamydomonas reinhardtii. Plant. Cell Physiol. 2013, 54, 1585–1599. [Google Scholar] [CrossRef]
- Neupert, J.; Karcher, D.; Bock, R. Generation of Chlamydomonas strains that efficiently express nuclear transgenes. Plant. J. 2009, 57, 1140–1150. [Google Scholar] [CrossRef]
- Gorman, D.S.; Levine, R.P. Cytochrome f and plastocyanin: Their sequence in the photosynthetic electron transport chain of Chlamydomonas reinhardi. Proc. Natl. Acad. Sci. USA 1965, 54, 1665–1669. [Google Scholar] [CrossRef]
- Kindle, K.L. High-frequency nuclear transformation of Chlamydomonas reinhardtii. Proc. Natl. Acad. Sci. USA 1990, 87, 1228–1232. [Google Scholar] [CrossRef]
- Wichmann, J.; Baier, T.; Wentnagel, E.; Lauersen, K.J.; Kruse, O. Tailored carbon partitioning for phototrophic production of (E)-alpha-bisabolene from the green microalga Chlamydomonas reinhardtii. Metab. Eng. 2018, 45, 211–222. [Google Scholar] [CrossRef]
- Lauersen, K.J.; Kruse, O.; Mussgnug, J.H. Targeted expression of nuclear transgenes in Chlamydomonas reinhardtii with a versatile, modular vector toolkit. Appl. Microbiol. Biotechnol. 2015, 99, 3491–3503. [Google Scholar] [CrossRef]
- Schindelin, J.; Arganda-Carreras, I.; Frise, E.; Kaynig, V.; Longair, M.; Pietzsch, T.; Preibisch, S.; Rueden, C.; Saalfeld, S.; Schmid, B.; et al. Fiji: An open-source platform for biological-image analysis. Nat. Methods 2012, 9, 676–682. [Google Scholar] [CrossRef]
- Nito, K.; Kamigaki, A.; Kondo, M.; Hayashi, M.; Nishimura, M. Functional classification of Arabidopsis peroxisome biogenesis factors proposed from analyses of knockdown mutants. Plant. Cell Physiol. 2007, 48, 763–774. [Google Scholar] [CrossRef]
- Veenhuis, M.; Mateblowski, M.; Kunau, W.H.; Harder, W. Proliferation of microbodies in Saccharomyces cerevisiae. Yeast 1987, 3, 77–84. [Google Scholar] [CrossRef] [PubMed]
- Gurvitz, A.; Hamilton, B.; Ruis, H.; Hartig, A. Peroxisomal degradation of trans-unsaturated fatty acids in the yeast Saccharomyces cerevisiae. J. Biol. Chem. 2001, 276, 895–903. [Google Scholar] [CrossRef] [PubMed]
- James, G.O.; Hocart, C.H.; Hillier, W.; Chen, H.; Kordbacheh, F.; Price, G.D.; Djordjevic, M.A. Fatty acid profiling of Chlamydomonas reinhardtii under nitrogen deprivation. Bioresour. Technol. 2010, 102, 3343–3351. [Google Scholar] [CrossRef] [PubMed]
- Karp, P.D.; Billington, R.; Caspi, R.; Fulcher, C.A.; Latendresse, M.; Kothari, A.; Keseler, I.M.; Krummenacker, M.; Midford, P.E.; Ong, Q.; et al. The BioCyc collection of microbial genomes and metabolic pathways. Brief. Bioinform. 2019, 20, 1085–1093. [Google Scholar] [CrossRef] [PubMed]
- Kong, F.; Burlacot, A.; Liang, Y.; Legeret, B.; Alseekh, S.; Brotman, Y.; Fernie, A.R.; Krieger-Liszkay, A.; Beisson, F.; Peltier, G.; et al. Interorganelle Communication: Peroxisomal MALATE DEHYDROGENASE2 Connects Lipid Catabolism to Photosynthesis through Redox Coupling in Chlamydomonas. Plant. Cell 2018, 30, 1824–1847. [Google Scholar] [CrossRef]
- Chauvin, L.; Tural, B.; Moroney, J.V. Chlamydomonas reinhardtii Has Genes For Both Glycolate Oxidase and Glycolate Dehydrogenase. In Proceedings of the Photosynthesis. Energy from the Sun; Springer: Dordrecht, The Netherlands, 2008; pp. 823–827. [Google Scholar]
- Fang, Y.; Morrell, J.C.; Jones, J.M.; Gould, S.J. PEX3 functions as a PEX19 docking factor in the import of class I peroxisomal membrane proteins. J. Cell Biol. 2004, 164, 863–875. [Google Scholar] [CrossRef]
- Blum, M.; Chang, H.Y.; Chuguransky, S.; Grego, T.; Kandasaamy, S.; Mitchell, A.; Nuka, G.; Paysan-Lafosse, T.; Qureshi, M.; Raj, S.; et al. The InterPro protein families and domains database: 20 years on. Nucleic Acids Res. 2021, 49, D344–D354. [Google Scholar] [CrossRef]
- Imam, S.; Schauble, S.; Valenzuela, J.; Lopez Garcia de Lomana, A.; Carter, W.; Price, N.D.; Baliga, N.S. A refined genome-scale reconstruction of Chlamydomonas metabolism provides a platform for systems-level analyses. Plant. J. 2015, 84, 1239–1256. [Google Scholar] [CrossRef]
- Young, D.Y.; Shachar-Hill, Y. Large fluxes of fatty acids from membranes to triacylglycerol and back during N-deprivation and recovery in Chlamydomonas. Plant. Physiol. 2021, 185, 796–814. [Google Scholar] [CrossRef]
- Rucktaschel, R.; Girzalsky, W.; Erdmann, R. Protein import machineries of peroxisomes. Biochim. Biophys. Acta 2011, 1808, 892–900. [Google Scholar] [CrossRef]
- Huber, A.; Koch, J.; Kragler, F.; Brocard, C.; Hartig, A. A Subtle Interplay Between Three Pex11 Proteins Shapes De Novo Formation and Fission of Peroxisomes. Traffic 2012, 13, 157–167. [Google Scholar] [CrossRef]
- Li-Beisson, Y.; Kong, F.; Wang, P.; Lee, Y.; Kang, B.H. The disassembly of lipid droplets in Chlamydomonas. New Phytol. 2021, 231, 1359–1364. [Google Scholar] [CrossRef]
- Neupert, J.; Gallaher, S.D.; Lu, Y.; Strenkert, D.; Segal, N.; Barahimipour, R.; Fitz-Gibbon, S.T.; Schroda, M.; Merchant, S.S.; Bock, R. An epigenetic gene silencing pathway selectively acting on transgenic DNA in the green alga Chlamydomonas. Nat. Commun. 2020, 11, 6269. [Google Scholar] [CrossRef]
- Tirumani, S.; Gothandam, K.M.; Rao, J.B. Coordination between photorespiration and carbon concentrating mechanism in Chlamydomonas reinhardtii: Transcript and protein changes during light-dark diurnal cycles and mixotrophy conditions. Protoplasma 2019, 256, 117–130. [Google Scholar] [CrossRef]
- Reboud, X.; Bell, G. Experimental evolution in Chlamydomonas. III. Evolution of specialist and generalist types in environments that vary in space and time. Heredity 1997, 78, 507. [Google Scholar] [CrossRef]
- Flugge, U.I.; Hausler, R.E.; Ludewig, F.; Gierth, M. The role of transporters in supplying energy to plant plastids. J. Exp. Bot. 2011, 62, 2381–2392. [Google Scholar] [CrossRef] [PubMed]
- Govorunova, E.G.; Jung, K.H.; Sineshchekov, O.A.; Spudich, J.L. Chlamydomonas sensory rhodopsins A and B: Cellular content and role in photophobic responses. Biophys. J. 2004, 86, 2342–2349. [Google Scholar] [CrossRef]
- Finet, C.; Timme, R.E.; Delwiche, C.F.; Marletaz, F. Erratum: Multigene phylogeny of the green lineage reveals the origin and diversification of land plants. Curr. Biol. 2012, 22, 1456–1457. [Google Scholar] [CrossRef] [PubMed]
- Finet, C.; Timme, R.E.; Delwiche, C.F.; Marletaz, F. Multigene phylogeny of the green lineage reveals the origin and diversification of land plants. Curr. Biol. 2010, 20, 2217–2222. [Google Scholar] [CrossRef] [PubMed]
- Hayashi, Y.; Shinozaki, A. Visualization of microbodies in Chlamydomonas reinhardtii. J. Plant Res. 2012, 125, 579–586. [Google Scholar] [CrossRef]

| Excitation (nm) | Emission (nm) | |
|---|---|---|
| CFP | 458 | 468–500 |
| FL-C16 | 500 | 510–530 |
| RFP | 555 | 562–591 |
| Chlorophylls | 458 | 697–800 |
| PEX Genes | Saccharomyces Cerevisiae | Yarrowia Lipolytica | Hansenula (Ogataea) Polymorpha | Neurospora Crassa | Drosophila Melanogaster | Mus Musculus | Homo Sapiens | Arabidopsis Thaliana | Chlamydomonas Reinhardtii | Phytozome Accession | Description |
|---|---|---|---|---|---|---|---|---|---|---|---|
| PEX 1 | ✓ | ✓ | ✓ | ✓ | ✓ | ✓ | ✓ | ✓ | ✓ | Cre16.g679200 | peroxisome biogenesis factor 1 |
| PEX 2 | ✓ | ✓ | ✓ | ✓ | ✓ | ✓ | ✓ | ✓ | ✓ | Cre17.g698800 | predicted e3 ubiquitin ligase |
| PEX 3 | ✓ | ✓ | ✓ | ✓ | ✓ | ✓ | ✓ | ✓ | ✓ * | Cre14.g618450 | non-specific serine/threonine protein kinase |
| PEX 4 | ✓ | ✓ | ✓ | ✓ | ✓ | ✓ | Cre05.g240150 | ubiquitin-conjugating enzyme e2-21 kda | |||
| PEX 5 | ✓ | ✓ | ✓ | ✓ | ✓ | ✓ | ✓ | ✓ | ✓ | Cre14.g616750 | peroxisomal targeting signal 1 receptor PEX5 |
| PEX 6 | ✓ | ✓ | ✓ | ✓ | ✓ | ✓ | ✓ | ✓ | ✓ | Cre10.g446250 | peroxisome assembly factor 2 |
| PEX 7 | ✓ | ✓ | ✓ | ✓ | ✓ | ✓ | ✓ | ✓ | ✓ | Cre17.g730200 | peroxisomal targeting signal 2 receptor PEX7 |
| PEX 8 | ✓ | ✓ | ✓ | ✓ | |||||||
| PEX 10 | ✓ | ✓ | ✓ | ✓ | ✓ | ✓ | ✓ | ✓ | ✓ | Cre07.g337050 | peroxisome assembly protein 10 |
| PEX 11 | ✓ | ✓ | ✓ | ✓ | ✓ | ✓ | ✓ | ✓ | ✓ | Cre06.g263300 | peroxisomal biogenesis factor 11 |
| PEX 12 | ✓ | ✓ | ✓ | ✓ | ✓ | ✓ | ✓ | ✓ | ✓ | Cre06.g263602 | peroxisome assembly protein 12 peroxin-12 |
| PEX 13 | ✓ | ✓ | ✓ | ✓ | ✓ | ✓ | ✓ | ✓ | ✓ | Cre13.g574700 | peroxisomal membrane protein PEX13 |
| PEX 14 | ✓ | ✓ | ✓ | ✓ | ✓ | ✓ | ✓ | ✓ | ✓ | Cre10.g454025 | peroxisomal membrane protein PEX14 |
| PEX 15 | ✓ | no hits: Sc PEX15 | |||||||||
| PEX 16 | ** | ✓ | ✓ | ✓ | ✓ | ✓ | ✓ | ✓ | Cre11.g467758 | peroxisomal membrane protein PEX16 | |
| PEX 17 | ✓ | ✓ | ✓ | ✓ *** | no hits: Sc PEX or At PUP7 | ||||||
| PEX 18 | ✓ | ||||||||||
| PEX 19 | ✓ | ✓ | ✓ | ✓ | ✓ | ✓ | ✓ | ✓ | ✓ | Cre02.g119000 | peroxisomal farnesylated protein |
| PEX 20 | ✓ | ✓ | ✓ | ✓ | no hits: Sc and Nc PEX20 | ||||||
| PEX 21 | ✓ | no hits: Sc PEX21 | |||||||||
| PEX 22 | ✓ | ✓ | ✓ | ✓ | ✓ | ✓ | Cre06.g283150 | ||||
| PEX 23/30 | ✓ | ✓ | ✓ | ✓ | ✓ | ✓ | |||||
| PEX 24/28 | ✓ | ✓ | ✓ | ✓ | |||||||
| PEX 25 | ✓ | ✓ | ✓ | ||||||||
| PEX 26 | ✓ * | ✓ | ✓ | ✓ | ✓ | no hits: Hs or Mm PEX26 | |||||
| PEX 27 | ✓ | ✓ | Cre12.g540500 | peroxisomal membrane protein PMP27 | |||||||
| PEX 29 | ✓ | ✓ | ✓ | no hits: Sc PEX29 | |||||||
| PEX 31 | ✓ | no hits: Sc PEX31 | |||||||||
| PEX 32 | ✓ | ✓ | no hits: Sc PEX32 | ||||||||
| PEX 33 | ✓ | no hits: Sc PEX33 | |||||||||
| PEX 34 | ✓ | no hits: Sc PEX34 | |||||||||
| Smith and Aitchison (2013) | This work | ||||||||||
| Nito et al., (2007) | |||||||||||
Publisher’s Note: MDPI stays neutral with regard to jurisdictional claims in published maps and institutional affiliations. |
© 2022 by the authors. Licensee MDPI, Basel, Switzerland. This article is an open access article distributed under the terms and conditions of the Creative Commons Attribution (CC BY) license (https://creativecommons.org/licenses/by/4.0/).
Share and Cite
Kato, N.; McCuiston, C.; Szuska, K.A.; Lauersen, K.J.; Nelson, G.; Strain, A. Chlamydomonas reinhardtii Alternates Peroxisomal Contents in Response to Trophic Conditions. Cells 2022, 11, 2724. https://doi.org/10.3390/cells11172724
Kato N, McCuiston C, Szuska KA, Lauersen KJ, Nelson G, Strain A. Chlamydomonas reinhardtii Alternates Peroxisomal Contents in Response to Trophic Conditions. Cells. 2022; 11(17):2724. https://doi.org/10.3390/cells11172724
Chicago/Turabian StyleKato, Naohiro, Clayton McCuiston, Kimberly A. Szuska, Kyle J. Lauersen, Gabela Nelson, and Alexis Strain. 2022. "Chlamydomonas reinhardtii Alternates Peroxisomal Contents in Response to Trophic Conditions" Cells 11, no. 17: 2724. https://doi.org/10.3390/cells11172724
APA StyleKato, N., McCuiston, C., Szuska, K. A., Lauersen, K. J., Nelson, G., & Strain, A. (2022). Chlamydomonas reinhardtii Alternates Peroxisomal Contents in Response to Trophic Conditions. Cells, 11(17), 2724. https://doi.org/10.3390/cells11172724

